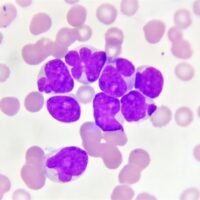

Category: Diseases & Treatments
A new gene therapy can reverse the effects of heart failure and restore heart function in a large animal model. The therapy increases the amount of blood the heart …
US cohort study highlights dark chocolate’s potential role in reducing type 2 diabetes risk, while milk chocolate consumption is associated with weight gain. Study: Chocolate intake and risk of type …
A review highlights the potential benefits of nutrients like omega-3 fatty acids, polyphenols, and plant-based proteins for IBD management, emphasizing the need for further research to personalize treatments. Study: The …
Smokers with myelodysplastic syndromes (MDS) or a precursor condition had elevated levels of genetic mutations linked to the disease, a new study shows. The study also found that heavier …
Despite a fall in the number of people with asthma over the past decade who say that cost has stopped them taking their meds as prescribed, financial hardship still …
Research reveals how adjusting breakfast timing and post-meal walks can transform glycemic control in type 2 diabetes, offering an easy lifestyle tweak for better health. Study: Modifying the timing …
New research from the Institute of Psychiatry, Psychology & Neuroscience (IoPPN) at King’s College London provides valuable insights into the brain-body immune connection identifying key communication hubs in the …
Three clinical trials led by researchers from The University of Texas MD Anderson Cancer Center demonstrated significant positive results from novel triplet therapies in the treatment of relapsed or refractory …
New RAND research identifies early predictors of cognitive impairment and dementia using a nationally representative U.S. dataset, highlighting the role of modifiable factors and baseline cognitive health in prevention …
Imagine an artificial intelligence (AI) model that can watch and understand moving images with the subtlety of a human brain. Now, scientists at Scripps Research have made this a …